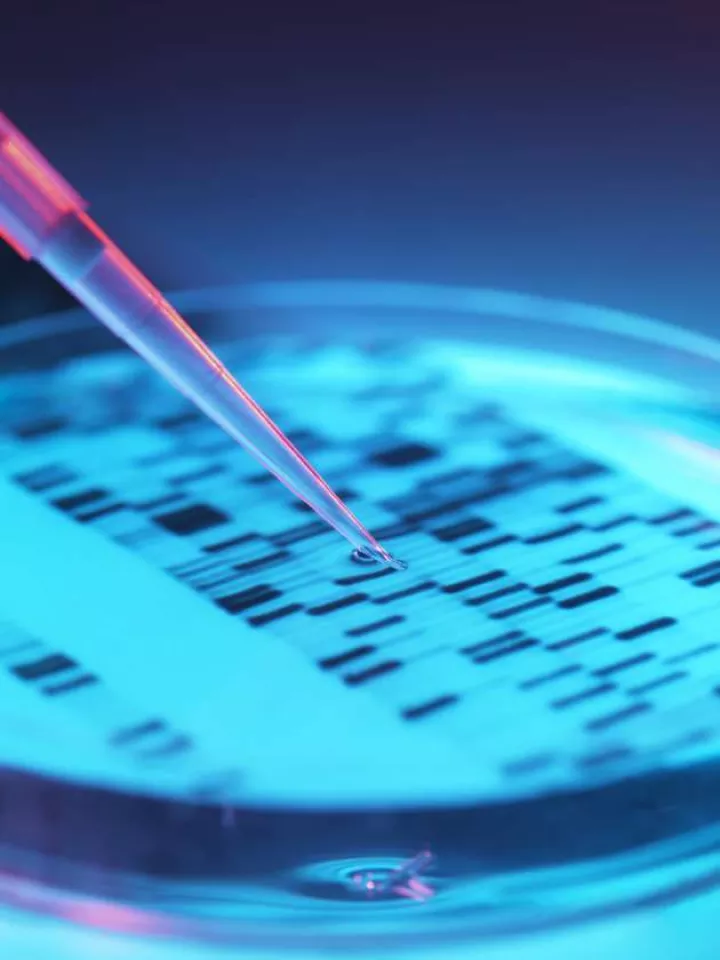
research-division-of-critical-care

The Division of Critical Care Medicine at the Albert Einstein College of Medicine is one of the nation’s leading academic programs serving as a center of academic and clinical excellence. We provide clinical and academic oversight of all adult medical, surgical, neurosurgical, and cardiothoracic intensive care units at Montefiore Medical Center, Weiler and Wakefield Hospital. Our faculty are recognized as national leaders in clinical care delivery and operation, research, and education. We strive to provide world class care to the Bronx community.
Featured Videos

Video could not be played
CBS News 'Bravery and Hope: 7 Days on the Front Line'.
Contact Us
-
Albert Einstein College of Medicine
Jack D. Weiler Hospital
1825 Eastchester Road
Bronx, NY 10461 -
Physicians and Patients
866-MED-TALK (866-633-8255)